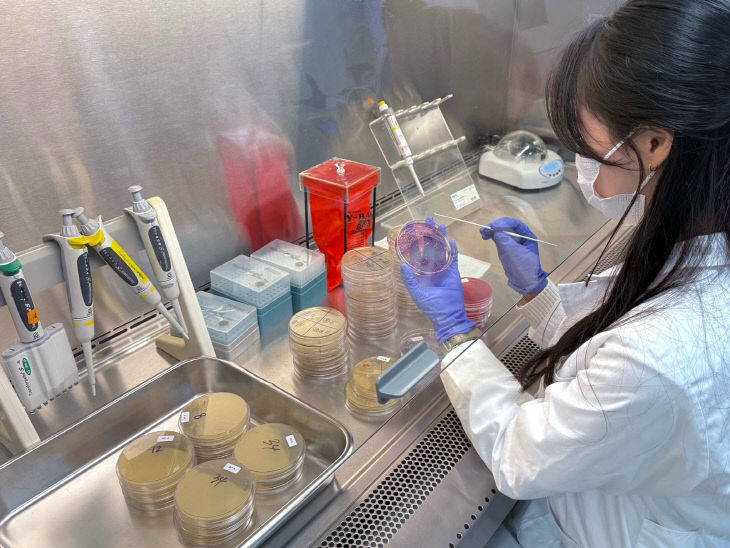
충북보환연, 도내 학교급식 안전성 검사 결과 ‘모두 적합’

![]() |
| 충북보건환경연구원은 올해 4월부터 11월까지 도내 초.중.고 42개교를 대상으로 학교급식 안전성 검사를 실시했다.(사진=충북보건환경연구원 제공) |
이번 검사는 집단급식시설에서 조리식품, 조리기구, 조리환경 표면 등을 선제적으로 점검해 교차오염으로 인한 집단 식중독 발생을 사전에 예방하기 위해 추진됐다.
검사 결과, 조리식품 및 환경검체 등 총 168건에서 주요 식중독 원인균 3종(살모넬라, 황색포도상구균, 대장균)이 모두 불검출되어 도내 학교급식의 안전성을 확인했다.
보존식 용기·배식대·배식용 앞치마 등 환경검체 126건을 대상으로 식중독 바이러스 5종(그룹A형로타바이러스, 아스트로바이러스, 장내아데노바이러스, 노로바이러스, 사포바이러스)을 추가 검사한 결과, 모두 불검출로 나타나 학교급식 내부 환경 역시 안전한 것으로 확인됐다.
충북보건환경연구원 윤방한 미생물과장은 "학교급식 위생·안전 관리를 강화하여 집단 식중독 발생을 사전에 차단하고, 학부모와 학생이 모두 안심할 수 있는 급식환경 조성에 최선을 다하겠다"며 "앞으로도 학교급식 안전성 검사를 지속적으로 확대해 나가겠다"라고 밝혔다.
청주=엄재천 기자 jc0027@
중도일보(www.joongdo.co.kr), 무단전재 및 수집, 재배포 금지
엄재천 기자